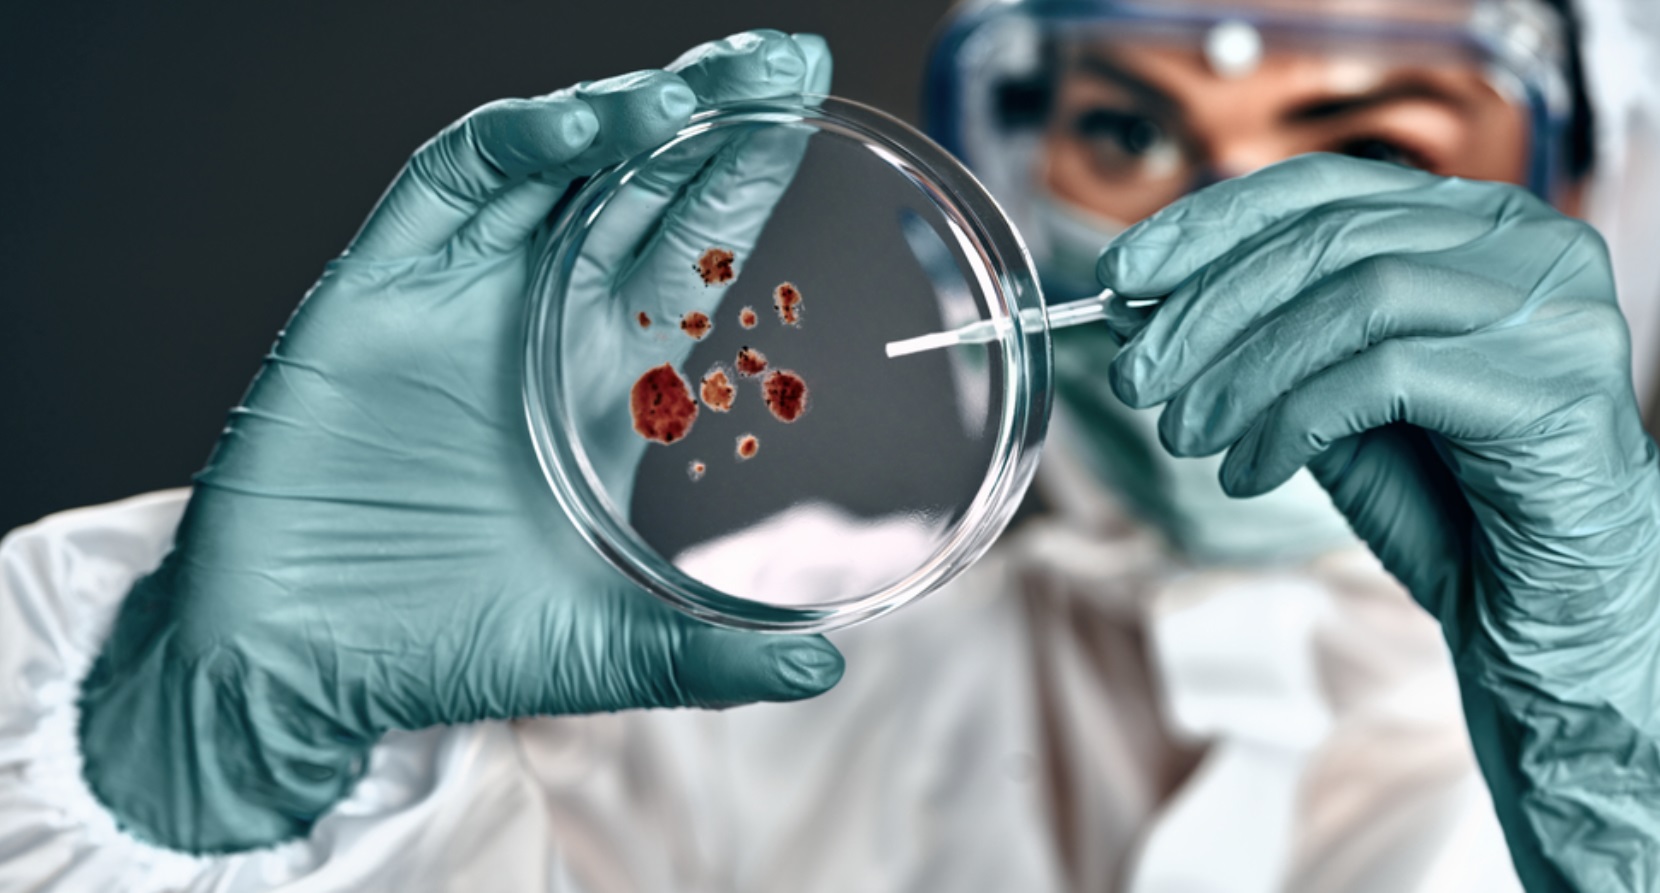
BSGN Life Science Industry Accelerator – 2nd Call for projects !

The mission of the BSGN Life Science Industry Accelerator is to:
- Involve new stakeholders from the biomanufacturing, biotechnology, pharmaceutical, nutraceutical and cosmetics sectors
-
Accelerate projects to prepare them for Low Earth Orbit (LEO) flight implementation with space commercial space providers
-
Directly co-fund projects for flight implementation or identify and access the most relevant ESA co-funding tools
-
Support projects that address terrestrial challenges through the unique advantages of the space environment, combined with space technologies and infrastructures
-
Collaborate with the European commercial space ecosystem in LEO
-
Foster the development of high-potential commercial activities
-
Attract new funding sources beyond ESA